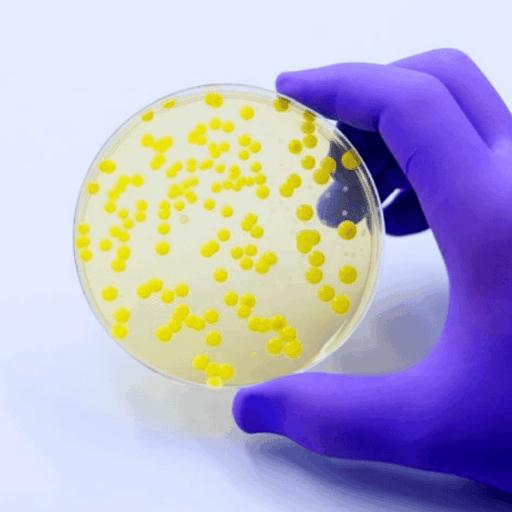

From AI-driven medical miracles to whisky made on a remote Arctic island, our latest issue is packed with fascinating stories and inspiring ideas
Artificial intelligence is still very divisive. We don’t love AI writing pop songs but we don’t mind that it’s turbo-boosting medical breakthroughs. Whether it’s intelligent stethoscopes that can detect future heart conditions in seconds, or AI-developed antibiotics, there are plenty of benefits from AI still to come.
Image: TopMicrobialStock

Last week’s Frieze Art Fair in London exhibited some of the world’s most successful artists (and some eye-wateringly expensive art), but you don’t need years at art school – or Jay Jopling on speed dial – to make it big in the art world. Mumbai-based art collective Chamar Studio has been taking the art world by storm with its chairs, bags, and accessories all created by former Dalits – among India’s most marginalised citizens – who have switched from working with leather to working with rubber tyres.
Image: Chamar Studios

In recent months South Korea and Sweden have banned smartphones in schools. The UK government has only issued guidance encouraging schools to prohibit phones during the school day, but are we at a tipping point that could see much of the world ensure mobiles are kept away from the classroom?
Image: Dobrila Vignjevic

Low streaming royalties, a cost of living crisis and a volatile landscape of grassroots venue closures mean the challenges have never been greater for independent musicians. But a number of funds, community groups and artist-to-artist support programmes are helping to keep Britain’s musical heart beating.
Image: Dean Chalkley

Hoodie-wearing teenage boys hunched over a screen in their mum’s dark basement is an image often conjured up when thinking of a typical hacker. So what a pleasant surprise to discover the ethical hacker Betta Lyon Delsordo, who supports young women wanting to get into the tech industry – and stop the bad guys before they cause harm.
Image: Greg Khan

Sam Ryder has already become something of a British institution since representing the UK in the 2022 Eurovision Song Contest. As he explains in this issue, it wasn’t until he was 31 that he achieved his dream of becoming a musician – a career he had aspired to since he was just 14 years old.
Image: Jack Robinson

We all know of the Olympic Games, the Commonwealth Games and, more recently, the Invictus Games, established by Prince Harry for wounded military veterans. But at this year’s World Transplant Games, held in Germany, more than 2,500 transplant patients from 51 countries took part to thank and celebrate their second chance at life.
Image:WTG2025/YesVideography

Surely whisky comes from Scotland, not some tiny, windswept outcrop miles out into the Arctic Ocean, right? Our editor, Tom Pattinson, travelled several days to reach this remote Norwegian island, where its tiny population of just 12 permanent residents has banded together to save their dying community by creating this unusual spirit.
Image: Julie Luneborg

Plastic goes in one bin, glass goes in another – but where to put that unused, unwanted and unwieldy cello? Look no further. A growing number of musical recycling centres have emerged in recent years due to a glut of instruments that flooded the market during those slow lockdown years. Now they’re being rebuilt and rehomed to provide instruments for those who can’t afford them.
Image: Jack Roe

Late nights, dark basements, sticky floors, lots of swearing – this is what usually springs to mind when we think of a ‘comedy club’. But a new wave of comedy clubs is opening on midweek mornings, catering for new mums in need of a laugh.
Image: Ultra Comedy
Main image: Julie Luneborg





